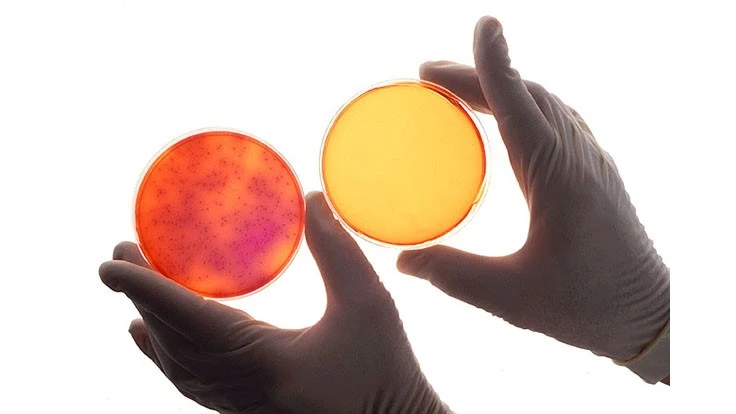
USDA-ARS

USDA-ARS
FSIS is making available a list of test kits that have been validated for detection of relevant foodborne pathogens.
FSIS is making available a list of test kits that have been validated for detection of relevant foodborne pathogens (i.e., Salmonella, Campylobacter, E. coli O157:H7, Listeria spp. including L. monocytogenes, and non-O157 STECs). These lists are intended to be informational and are not an endorsement or approval of any particular method, regardless of its inclusion in the list.
While FSIS does not require the use of any particular test method, the method chosen by an establishment should be:
- Validated for testing relevant foods by:
- a recognized independent body (i.e., AOAC, AFNOR, MicroVal, NordVal), or
- a U.S. regulatory body (i.e. FSIS MLG or FDA BAM), or an ISO method
- The validated method should be:
- Fit for the intended purpose and application, and
- Performed under validated conditions by a laboratory that assures the quality of the analytical results.
The USDA Validated Test Kit Table contains a list of foodborne pathogen test kits that meet criterion 1a (i.e., are validated by recognized independent organizations (e.g., AOAC, AOACPTM, AFNOR, MicroVal, NordVal), but none are implicitly approved by USDA FSIS. A validated test kit must also be fit for purpose (i.e., validated for the appropriate matrix and sample size) and appropriate for the specific application in a food safety program. Additionally, these methods should be performed as per the conditions of the validated protocol by a laboratory that assures the analytical results.
FSIS also has published further guidance for choosing a microbiological laboratory. The sampling methodology and frequency must be appropriate to answer the food safety question that is asked. Finally, sample transport and storage should be appropriate to ensure the integrity of the sample and the result.
The methods listed are not necessarily equivalent or appropriate for all specific testing applications, rather users should refer to other FSIS guidance on fitness for purpose for specific applications. As an example, AskFSIS provides guidance on appropriate test portions for E. coli O157:H7 testing and application of non-culture confirmation methods to confirm screening test results. For Listeria food contact surface and other environmental samples, FSIS states that validated methods should include an enrichment step for the entire sponge, swab, or sampling device. Methods listed on the table do not necessarily meet all of these criteria. For more detail on RTE Listeria, FSIS has published RTE Listeria Compliance Guidelines.
On a case-by-case basis, FSIS has reviewed robust studies using the FSIS MLG method as a reference method. For these reviews, FSIS uses the FSIS Test Kit validation guidelines to evaluate the study design, results, and data analysis for these alternative methods. These alternative methods are not included in the lists because they are not externally validated by an independent organization.
FSIS intends to update validated test kit lists on a quarterly basis. For more information and the table, see USDA Validated Test Kit table.
Latest from Quality Assurance & Food Safety
- Freshpet Becomes First Dog Food to Earn Clean Label Project Certification
- Saputo Recalls Great Value Cottage Cheese Due to Possible Pasteurization Issue
- FDA Updates Infant Formula Resources
- Pitch Competition Returns to IFT FIRST Annual Event and Expo
- Sterling Expands GPL and LHE Chiller Lines for Use in Food and Beverage Production
- FDA Releases Produce Regulatory Program Standards
- Invest in People or Risk the System: Darin Detwiler and Catalyst Food Leaders on Building Real Food Safety Culture
- USDA Proposes Increasing Poultry, Pork Line Speeds





